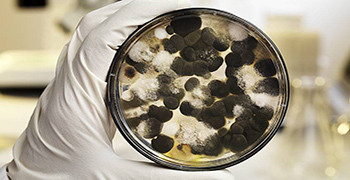
防霉劑廠家告訴你為什么要做防霉？防霉的意義在哪里？

-
發布時間:2020-06-11在雨季頻繁的時候,我們該如何做好木質家具的防霉防潮措施呢?今天霉博士就來教教大家!一般來說,木質家具出廠前肯定是經過了嚴格的干燥處理程序,但這并不意為著后期就可以不做防潮及防霉措施
-
-
發布時間:2020-06-10鞋子發霉讓很多人都很頭大吧,鞋子一旦受潮,若不及時清洗曬干的話,就很容易出現發霉的現象。那面對鞋子發霉的情況,我們要怎么處理才有效呢!今天除霉劑廠家就給大家準備了幾類鞋子的除霉方法
-
發布時間:2020-06-10沙發是家具中必不可少的一個角色,根據家庭裝修風格的不同,人們所挑選的沙發也會有所不同,將沙發按材質分類的話,可分為:皮質的、布藝的、實木的、絲絨的等等,可是沙發也是特別容易發霉的,
-
發布時間:2020-06-09要知道霉變就在我們的日常生活中,那我們該如何做好日常生活的防霉呢?霉菌喜溫喜濕,在溫暖和潮濕的環境下,極其容易生長和繁殖,除食物外,家具、衣物、地板,甚至墻面都容易在多雨季發霉,一
-
-
發布時間:2020-06-08想必很多人對于塑料制品發霉了,會存在些許的疑惑甚至搞不清楚原因,其實大多數純粹的高分子化合物均具有抗霉性,不會被微生物的酶所分解或消化,但塑料中的某些添加劑卻會影響制品的抗霉性,如
-
發布時間:2020-06-08帆布袋也會發霉嗎?如何做好帆布袋的防霉措施!霉博士今天就給大家好好科普一下,所謂帆布就是一種比較粗厚的棉織物或麻織物,一般把帆布分為粗帆布和細帆布兩種,帆布的應用十分廣泛,而帆布袋
-
發布時間:2020-06-06防霉劑廠家告訴你為什么要做防霉:“伴隨著科學技術的進步,工業的快速發展,人們對各種材料及其制品的質量和精密度也有著更高的要求。對于自我的身體健康也更加重視,因此展開防霉工作是十分有
-
發布時間:2020-06-06有些電線由于安裝年代比較久遠,就會出現發霉的情況,再加上許多電線所處的環境是過于潮濕和臟亂的,所以出現發霉一點也不奇怪,那電線易發霉,我們該如何做好它的防霉措施呢?今天霉博士就來和